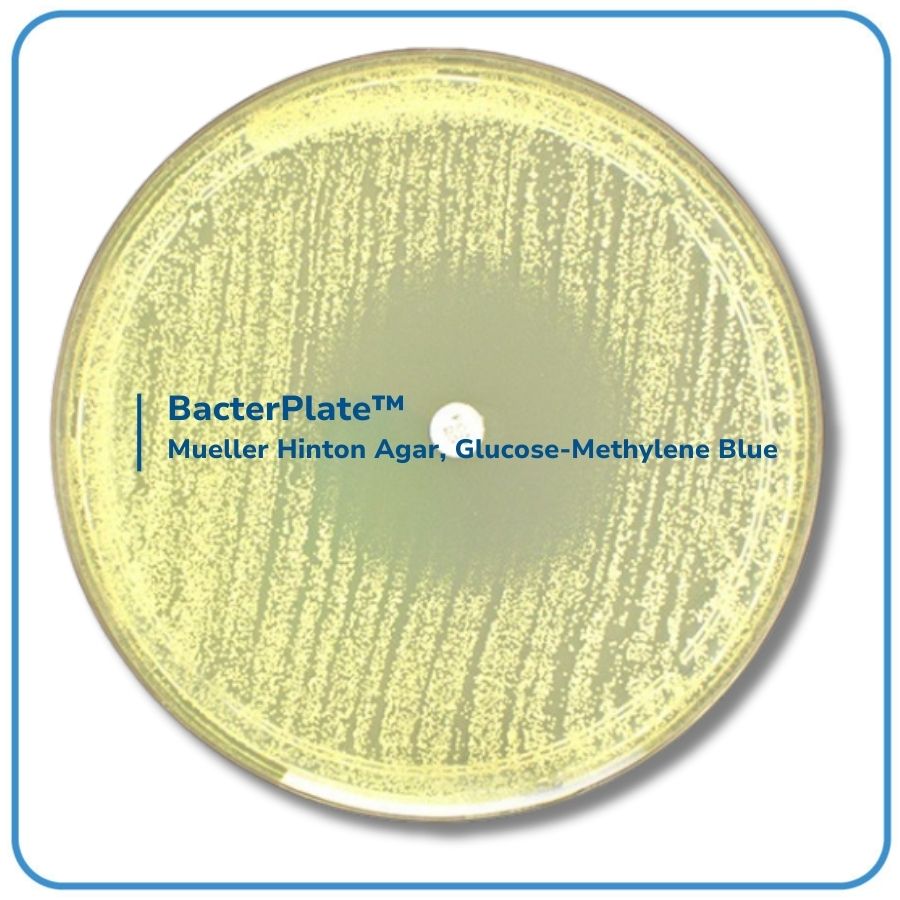

MỤC ĐÍCH SỬ DỤNG
- BacterPlate™ Mueller Hinton Agar, Glucose-Methylene Blue là môi trường chuyên biệt, được khuyến nghị để kiểm tra độ nhạy kháng nấm bằng phương pháp khuếch tán đĩa đối với các loài nấm men.
- Bao gói bằng màng bán thấm Cellophane film giúp cân bằng độ ẩm môi trường trong quá trình bảo quản.
NGUYÊN TẮC
- Beef infusion và casein acid hydrolysate cung cấp các hợp chất nitơ, carbon, lưu huỳnh và các chất dinh dưỡng thiết yếu khác.
- Starch hoạt động như một chất keo bảo vệ chống lại các chất độc trong môi trường. Sự thủy phân tinh bột tạo ra dextrose, là nguồn năng lượng.
- Glucose đóng vai trò là nguồn năng lượng cho các nấm men.
- Methylene blue tăng cường khả năng nhận diện rìa vùng ức chế.

English